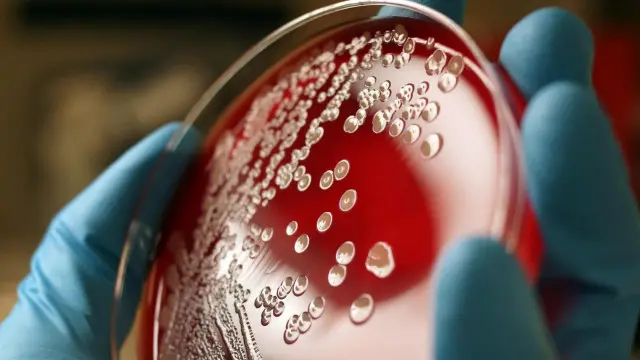
قد تؤوي المنطقة ما بين الأنامل والأظافر مئات الألاف من أنواع البكتيريا

احترس من البكتريا التي تعيش تحت أظافرك

صدر الصورة، Thinkstock
- Author, جيسون غولدمان
- Role, صحفي علمي
يعدّ غسل اليدين الوسيلة الأولى لوقاية الجسم من جميع أنواع البكتيريا الضارة، ولكن هل يمكنك أن تغسل الأجزاء الواقعة بين أناملك وأظافرك؟ ربما عليك أن تحرص على غسلها.
ربما تعرف أن غسل اليدين يعدّ أحد أفضل وسائل الوقاية من انتشار الجراثيم. وفي بعض المناطق، تُلزم قوانين الصحة العامة العاملين في مجال الخدمات ذات الصلة بالأطعمة بالمحافظة على نظافة أيديهم طوال الوقت. ومع ذلك، مهما نظفت اليدين وفركتهما، لن تتمكن من إزالة كل البكتريا العالقة بهما.
ولأن تعقيم اليدين أمرٌ مستحيل، يعمد الأطباء والممرضات إلى ارتداء القفازات في معظم الحالات عند ملامسة المرضى. ومنذ ما يقرب من مئة عام، بدأ الأطباء يدركون أن نتائج الفحوصات لا تخلو أبدًا من بعض الأنواع من البكتيريا، على الرغم من تكرار غسل اليدين مرات عديدة.
وحتى بداية سبعينيات القرن العشرين، لم يكن العلماء يعرفون تحديدًا أسباب تعذُّر التخلص من البكتيريا التي تعيش في اليدين إلى هذا الحد.
فقد تبيّن أن تغطية الأنامل قد تُبقي اليدين نظيفتين لفترة أطول. بيد أن البكتيريا لا يكثر وجودها في الأنامل، بل في الأظافر. إذ أن هذه الطبقة الواقية الرقيقة، أي الأظافر، المصنوعة من مادة الكيراتين البروتينية الصلبة، وهي نفس المادة التي تتكون منها قرون وحيد القرن و ظبي الإمبالا الأفريقي، تؤوي أنواعًا عديدة من البكتيريا.
ومنذ أواخر ثمانينيات القرن الماضي، بدأ العلماء يولون اهتمامًا للمنطقة الواقعة بين الأظافر والأنامل بحثًا عن الكائنات الدقيقة التي تعيش فيها. وفي هذا الصدد، أخذ ثلاثة باحثين من قسم الأمراض الجلدية بجامعة بنسلفانيا مسحات من أيدي 26 متطوعًا بالغًا، وكلهم موظفون بكلية الطب بالجامعة، ولم يسبق لهم ملامسة المرضى.
وقد اكتشفوا أن المساحة بين الأظافر والأنامل، التي تسمى منطقة تحت الأظافر، "أحد المواقع الهامة" التي تمثل مرتعًا للبكتيريا.
وعلى الرغم من أن ثمة أجزاءً أخرى من أيدي المتطوعين كانت تؤوي من مئات إلى آلاف الأنواع من البكتيريا، إلا أن نتائج تحاليل العينات المأخوذة من المنطقة الواقعة تحت الأظافر كشفت عن أن رأس كل إصبع يعج بمئات الآلاف من أنواع البكتيريا.
وهذا يعني أن الأظافر تؤوي نفس أنواع البكتيريا التي تعيش في سائر أجزاء اليد، ولكن أكثر عددًا باضعاف.

صدر الصورة، Thinkstock
وقد عزا الباحثون ذلك إلى وجود مساحة بين الجلد والظفر تشكل بيئة خصبة لتنمو فيها هذه الكائنات الدقيقة وتتكاثر، بفضل الحماية المادية التي يوفرها لها الظفر وكل هذه الرطوبة.
إن النتائج المستقاة من كل من الدراسات السابقة التي أفادت بأن فرك اليدين المتواصل لا يفيد في تعقيمهما، والدراسة التي أجراها الباحثون الثلاثة، والتي أفادت، حسبما جاء على لسان الباحثين "بوجود كم هائل من البكتيريا في المنطقة الواقعة تحت الأظافر، تشير إلى أن هذه المنطقة من اليدين لا تصل إليها العوامل المضادة للميكروبات نسبيًا أثناء عمليات غسل اليدين المعتادة".
وتأمّل معي إذن أن أفضل الوسائل المتاحة لمنع انتشار الأمراض وأبسطها على الإطلاق، لا يمكن أن تصل قط إلى المنطقة الواقعة بين الأظافر والأنامل.
وبالفعل، مازال أحد مجالات الأبحاث، وهو مجال صغير ولكنه يزداد توسعًا في الوقت الحالي، يسبر أغوار طبيعة حياة الميكروبات التي تعيش في أظافر الممرضات، ولم تقتصر الأبحاث في هذا المجال على فحص الأظافر الطبيعية، بل امتدت أيضًا لفحص الأظافر الاصطناعية والمطلية بطلاء الأظافر.
وفي عام 1989، أي بعد عام واحد من الدراسة التي أجريت في جامعة بنسلفانيا، كتبت مجموعة من الممرضات: "على الرغم من التساؤلات التي لم تُحسم بعد حول مدى آمان الأظافر الاصطناعية وصلاحيتها للاستخدام في مجال التمريض، فإن الكثير من العاملات في مجال الرعاية الصحية لم يقاومن إغراءات الموضة، ويضعن الآن أظافر اصطناعية".
وقد أجرى الباحثون مقارنة بين 56 ممرضة تضعن أظافر اصطناعية، والتي كثيرًا ما تكون أطول من الأظافر الطبيعية وتكاد تكون مغطاة دائمة بطلاء أظافر، و56 ممرضة لا تضعن أظافر صناعية، لمعرفة ما إن كانت أنامل الممرضات اللاتي يضعن أظافر صناعية تحوي بكتيريا أكثر من أنامل غيرهن من الممرضات اللاتي لا يضعن أظافر صناعية.
كما أراد الباحثون أن يعرفوا هل يجدي غسل اليدين نفعًا مع ذوات الأظافر الصناعية أكثر من غيرهم، أم العكس.

صدر الصورة، Getty Images
وقد اكتشفوا أن أنامل الممرضات اللاتي يضعن أظافر صناعية تحوي أنواعًا من البكتيريا أكثر من أنامل غيرهن من الممرضات اللاتي لا يضعن تلك الأظافر، سواء قبل غسل اليدين أو بعده.
وهذا لا يعني أن الممرضات اللاتي يضعن أظافر صناعية ينقلن بالضرورة أنواعًا أكثر من البكتيريا إلى مرضاهم، بل يثبت فقط أن أناملهن تؤوي بكتيريا أكثر عددًا وتنوعًا من غيرهم.
بيد أن هذا لا يمنع أنه كلما زادت أنواع البكتيريا، زادت على الأقل احتمالات انتقال الكائنات الدقيقة المسببة للأمراض من شخص إلى آخر.
وقد خلصت دراسات في المجال نفسه نشرت في عامي 2000 و2002، إلى نتائج مشابهة. ولكن في هذا الوقت، كان لدى الباحثين في مجال التمريض أدلة تثبت أن الأظافر الصناعية ترتبط ارتباطًا وثيقًا بالعادات الخاطئة المتبعة عند غسل اليدين، وذلك لم يزد المشكلة إلا تعقيدًا.
كما أدرك الباحثون أن الأظافر الصناعية من المرجح أن تقطع القفازات التي تستعمل لمرة واحدة.
أما الأظافر الطبيعية المطلية، فلها مشاكلها المختلفة. إذ تكمن المخاوف من طلاء الأظافر في أن التشققات التي تظهر على الطلاء ربما تؤوي أنواعا من البكتيريا.
وفي عام 1993، فحص ممرضون وممرضات من مستشفى جونز هوبكينز، في مدينة بالتيمور، بالولايات المتحدة، أنامل 26 امرأة بالغة كانت قد عينتهن المستشفى في مجالات غير الرعاية بالمرضى.
وكانت أظافرهن كلهن قصيرة، وخضعوا للاختبار قبل وضع طلاء الأظافر وبعد أربعة أيام من وضعه.
صدر الصورة، Getty Images
ويبدو أن الطلاء على الأظافر الطبيعية لا يؤثر على غزارة التنوع الحيوي البكتيري على الأنامل بالطريقة نفسها التي يؤثر بها على الأظافر الصناعية. ولكن خلُص الباحثون إلى أنه "سواء ُوِضع طلاء أظافر أم لم يوضع، فإن الأهم الحفاظ على الأظافر قصيرة ونظيفة".
وقد توصلت دراسة أخرى أُجريت في السنة اللاحقة إلى الاستنتاج نفسه. وبينما كانت الأظافر التي مرّ أربعة أيام على طلائها تحوي الكثير من البكتيريا، فإن الأظافر المطلية حديثًا كانت آمنة تمامًا.
وفي حين يقضي ما يقرب من مليوني إلى ثلاثة ملايين شخص نحبهم كل عام من جراء الإصابة بالإسهال، فإن البعض يرى أن غسل اليدين بالصابون ربما قد ينقذ حياة مليون منهم، بل من المرجح أن ينقذ حياة الكثيرين.
ولكن بالإضافة إلى غسل اليدين، من الواضح أن أفضل الخطوات التي عليك أن تتبعها، عندما تغسل يديك، هي أن تحرص كل الحرص، على إيصال الماء إلى المنطقة الواقعة تحت الأظافر، أي بين أظافرك وأناملك.
ولكي تحصل على أنامل طاردة للبكتيريا، فلتبقي أظافرك قصيرة ونظيفة. وكل ما سبق سيجعلك تتوقف وتعيد التفكير قبل أن تقضم أظافرك.
يمكنك قراءة <link type="page"><caption> الموضوع الأصلي</caption><url href="http://www.bbc.com/future/story/20160622-what-lives-under-your-fingernails" platform="highweb"/></link> على موقع <link type="page"><caption> BBC Future</caption><url href="http://www.bbc.com/future" platform="highweb"/></link>.








